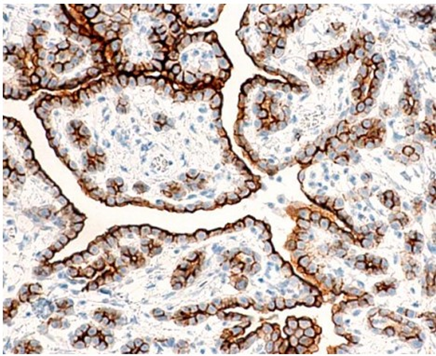

Effects of Hyperthermic Intraperitoneal Chemotherapy and Intraperitoneal Chemotherapy for Well-Differentiated Papillary Mesothelioma
by Yutaka Yonemura1-3*, Haruaki Ishibashi2, Ching-Hsien Ling2, Takuji Fujita2, Yang Liu2, Sachio Fushida2, Toshiyuki Kitai2, Yasuo Hirono2, Shouzou Sako2, Akiyoshi Mizumoto3, Nobuyuki Takao3, Keizou Taniguchi4, Daisuke Fujimoto4
1Asian School of Peritoneal Surface Malignancy Treatment, Kyoto City, Kyoto Prefecture, 600-8189, Japan
2Department of Regional Cancer Therapy, Peritoneal Dissemination Center, Kishiwada Tokushukai Hospital, Kishiwada City, Oosaka Prefecture, 596-8522, Japan
3Department of Regional Cancer Therapy, Peritoneal Dissemination Center, Kusatsu General Hospital, Kusatsu City, Shiga Prefecture, 525-8585n, Japan
4Department of Surgery, Mizonokuchi Hospital, Teikyo University, School of medicine, Kawasaki, Kanagawa, 213-8507, Japan
5Department of Surgical Oncology, The University of Tokyo, Tokyo 113-8654, Japan
*Corresponding author: Yutaka Yonemura, Representative of Asian School of Peritoneal Surface Malignancy Treatment, Department of Regional Cancer Therapies, Peritoneal Surface Malignancy Treatment Center, Kishiwada Tokushukai Hospital, Osaka, Japan
Received Date: 18 May 2024
Accepted Date: 23 May 2024
Published Date: 25 May 2024
Citation: Yonemura Y, Ishibashi H, Ling CH, Fujita T, Liu Y, et al. (2024) Effects of Hyperthermic Intraperitoneal Chemotherapy and Intraperitoneal Chemotherapy for Well-Differentiated Papillary Mesothelioma. J Surg 9: 11059 https://doi.org/10.29011/2575-9760.11059
Abstract
Objective: Well-Differentiated Papillary Mesothelioma (WDPM) is a rare disease, with no consensus recommendation for treatment. In the present article, we propose novel treatment options for the treatment of WDPM.
Methods: From 2006 to 2023, nine patients (five male, four femail) were pathologically classified as WDPM, ranging age from 35 to 65 years. One patient showed scattered peritoneal nodules, and was treated by Laparoscopic Hyperthermic Peritoneal Perfusion (LHIPEC) alone. The remaining eight patients had multifocal peritoneal involvement, four patients were treated with LHIPEC alone. Neoadjuvant Intraoperative Chemotherapy (NIC) was administered in five cases, using Docetaxel Plus Cisplatinum (CDDP) via an intraperitoneal port system. In five cases, laparotomy and peritonectomy was accompanied by intraoperative HIPEC. Complete macroscopic resection of peritoneal nodules (CC-0) achieved in two cases, but in two other cases, CC-0 could not be performed due to diffuse involvement of the small bowel mesentery. Second and third sessions of LHIPEC were performed in six cases.
Results: The peritoneal carcinomatosis index (PCI) after the first LHIPEC was 24.1 ± 8.9, and that after LHIPEC plus IP chemotherapy was16.9 ± 8.3 (N=6)(P=0.0124). Four patients treated with LHIPEC alone were alive with WDPM from 11 to 77 months or without recurrence after 92 months. The PCI for the scattered type was 3 at the 1st LHIPEC, reducing 0 at the second laparoscopy. The PCI for the multifocal type was 30 at the 1st LHIPEC, followed by completely disappearence of macroscopic nodules at the 2nd laparoscopy. In contrast, PCIs of 26 and 23 in two patients could not be reduced by LHIPEC and IP chemotherapy to the levels required for complete resection. This was due to diffuse involvement of the small bowel mesentery, One of these patients died from recurrent mesothelioma in the pleural cavity and abdominal wall with epihelioid malignant peritoneal mesothelioma on histology. She had microscopic invasive foci with atypical cells in part of resected specimen. The other case who had a peritoneal recurrence of biphasic mesothelioma is still alive.
Conclusions: Most of WDPM that are either solitary or have few nodules are thought to behave benignly, however, some multifocal WDPM contain highly malignant foci. Complete cytoreduction of visible nodules after LHIPEC and IP chemotherapy combined with intraoperative HIPEC are essential for cure. Patients with multifocal WDPM who have incomplete resection may develop recurrence due to occult invasive foci and transformation into MPM. Accordingly, the resected specimen should be studied carefully to detect invasive foci. Although most WDPM have indolent biological behavior, patients should be followed carefully for many years.
Keywords: HIPEC; Mesothelioma; Peritoneal cancer index; Peritoneal metastasis; Peritonectomy; WDPM; Well differentiated papillary mesothelioma
Introduction
Well-Differentiated Papillary Mesothelioma (WDPM) is one of the groups of peritoneal mesothelioma [1]. Deraco M et al. classified the disease as a borderline malignancy in malignant peritoneal mesothelioma (MPM), and occupies 10.4% (105/1103) of all MPM [2]. Most articles about WDPM reported that the biological characters of the disease show a benign course, but some cases progress to malignant transformation [3]. Accordingly, this disease has a broad spectrum of malignancy [4]. However, the incidence of WDPM is very rare, and no consensus for the recommendation of treatment option has been described. In the present article, we report the data of our experiences of 9 patients with WDPM, and propose some treatment options for the treatment of WDPM
Patients and Methods
From 2006 to 2023, 107 patients with MPM were referred to our hospitals, and 9 (8.4%), 84 (78.5%), 9 (8.4%) and 5 (4.7%) were pathologically classified into WDPM, epithelioid, biphasic, and sarcomatoid type, respectively, according to the classification of WHO from biopsied materials and resected specimens. Among 9 WDPM patients, 5 were male and 4 were female, and the age range from 35 to 65 with mean age of 45.1 years old (Table 1). Case one showed scattered nodules (5 small nodules of smaller than 5 mm in diameter on the small bowel mesentery and one nodule of 6 mm in diameter on the caecum) (Figure 1). Biopsied material showed typical papillary architecture containing fibrovasular cores with a single lining of cuboidal mesothelial cells without atypia or mitoses on the peritoneal surface. She was treated by Laparoscopic Hyperthermic Peritoneal Chemotherapy (LHIPEC) with 20mg of mitomycin C (MMC) and 100mg of cisplatinum (CDDP) (Tables 1,2). She is alive without recurrence 7 years after LHIPEC.

Figure 1: Scattered type of WDPM (case 1), 2-3 mm of several nodules were found on the small bowel mesentery.
The other 8 patients showed multifocal involvement of peritoneal surface with small nodules of 2-3 mm in diameter (Figure 2). Eight patients except case 6 were received laparoscopy and LHIPEC. Four patients (Case 1, 2, 5, and 7) were treated with LHIPEC alone, using MMC + CDDP for case 1 and 2 or MMC + Gemicitabine (1000mg/body) for case, 5 and 7. Neoadjuvant intraoperative chemotherapy (NIC) using 40mg of docetaxel plus 40mg of CDDP through intraperitoneal port system was performed in case 2, 3, 4, 7, and 8 (Table 3). In case 3, 4, 6, 8, and 9, laparotomy was performed and peritonectomy was done accompanying with intraoperative HIPEC. Complete macroscopic resection of peritoneal nodules (CCR-0) could be done in case 3, and 4, but in case 8, and 9, CCR-0 could not be performed due to diffuse involvement of small bowel mesentery. Specimens of all these 9 patients histologically shows a mesothelial proliferation with a papillary architecture, a myxoid appearance to the papillary cores , and a sigle layer of cytologically bland mesothelial cells covering the papillae, with small number of KI-67 labelled cells (Figure 5) and absence of invasion to other organs [5].

Figure 2: Diffuse type in WDPM (case 2), 2-3 mm of uncountable nodules were found on the greater omentum.
|
cases |
Age |
1st treatment |
Operation day |
CCR |
residual disease |
PCI |
*NLHIPEC |
NLHIPEC day |
|
1 |
35 |
6/18/2016 |
no |
yes |
0 |
MMC+CDDP |
6/18/2016 |
|
|
2 |
56 |
9/27/2018 |
no |
yes |
30 |
MMC+CDDP |
9/27/2018 |
|
|
3 |
55 |
3/8/2023 |
6/5/2023 |
0 |
no |
3 |
GEM+CDDP |
3/8/2023 |
|
4 |
52 |
4/8/2021 |
8/23/2021 |
0 |
no |
13 |
DTX+CDDP |
6/27/2021 |
|
5 |
48 |
5/31/2019 |
no |
yes |
16 |
GEM+CDDP |
5/27/2019 |
|
|
6 |
40 |
12/2/2015 |
5/23/2015 |
2 |
SBM |
23 |
no |
no |
|
7 |
52 |
10/26/2018 |
no |
yes |
39 |
GEM+CDDP |
10/12/2018 |
|
|
8 |
55 |
10/29/2013 |
10/29/2013 |
2 |
SBM** |
26 |
MMC+CDDP |
7/19/2013 |
|
9 |
65 |
1/17/2018 |
1/17/2018 |
2 |
SBM |
23 |
MMC+CDDP |
7/7/2017 |
|
*NLHIPEC: neoadjuvant intraperitoneal chemo hyperthermia |
||||||||
|
**SMB: small bowel mesentery |
||||||||
Table 1: Cases of well-differentiated papillary mesothelioma.
|
Case |
PCI at NLHIPEC |
intraoperative HIPEC |
prognosis |
subperitoneal invasion |
IP chemo |
|
1 |
3 |
7 years without recurrenece |
no |
No |
|
|
2 |
30, 0, 11 |
6 years alive with disease (PM) |
UK***** |
DC****** |
|
|
3 |
15 |
GEM*** |
2024/1/12; alive without recurrence |
no |
DC****** |
|
4 |
16 |
GEM+CDDP |
2024/1/8; alive without recurrence |
no |
DC****** |
|
5 |
16 |
2023/12/10 alive without recurrence |
UK |
0 |
|
|
6 |
no |
MMC+CDDP |
2020/2/20 died of suicide |
no |
0 |
|
7 |
36, 39, 37 |
2022/4/11 alive with disease |
UK |
DC****** |
|
|
8 |
20 |
MMC+CDDP |
2021/11/19; died of disease (epithelioid, DMPM) |
positive |
DC****** |
|
9 |
25 |
DTX+CDDP**** |
2021/2/3: recurrence (PM*; biphasic, DMPM) |
no |
0 |
|
****DTX: Docetaxel; UK: unknown; ***GEM: Gemcitabine; *****UK: unnown; *DC****: docetaxel+CDDP IP |
|||||
Table 2: PCI at NLHIPEC, intraoperative HIPEC, prognosis, subperitoneal invasion, and IP chemotherapy.
|
Case |
IP cycles |
Nivolumab |
removed peritoneal sectors |
|
1 |
no |
||
|
2 |
24 |
done |
|
|
3 |
7 |
no |
5 |
|
4 |
5 |
done |
8 |
|
5 |
0 |
done |
|
|
6 |
0 |
no |
9 |
|
7 |
2 |
no |
|
|
8 |
3 |
done |
6 |
|
9 |
0 |
done |
8 |
Table 3: Cycles of IP chemotherapy, treatment by Nivolumab, and removed peritonel sectors.
Methods of LHIPEC
Before LHIPEC, informed consent according to the institutional guideline was obtained from all patients. The patients were put under general anesthesia. A 12 mm blunt port was placed from the 2cm longitudinal incision above the umbilicus. A second trocar (12 mm) was placed in the right upper quadrant, following by a third trocar (12mm) in the left lower quadrant. A 5 mm trocar was added if necessary in the left upper quadrant. Most of the ascites was suctioned and the amount was measured with cytological examination. If there is no ascites, peritoneal wash cytology was done using aspirated saline recovered after intraperitoneal administration of 200 ml of saline.
Biopsy specimens were routinely taken from the peritoneal nodules. Quantitative evaluation of peritoneal metastasis in the entire abdominal cavity was done using the Peritoneal Carcinomatosis Index (PCI) based on the regions involved in the abdominal cavity and the lesion size [6]. Following the confirmation of the diagnosis and PCI determination, a longitudinal 5cm midline incision was made on the midline of the lower abdomen for open laparotomy. Three drainage tubes were place on the bilateral subdiaphragmatic space for the inlet tubes and on the rectovesical pouch for male and Douglas’ pouch for female patients for an outlet tube. One liter of saline was introduced into the peritoneal cavity, and the saline was completely washed out. The procedure was repeated for ten times to remove the peritoneal free cancer cells (PFCCs) [7]. Then, LHIPEC was performed at 43 to 43.5 centigrade for 60 minutes adding 4 liters of saline with 20mg of MMC plus 50mg of CDDP in case 1, 2, 8, and 9, and 1000 mg of gemcitabine plus 50mg of CDDP in case 3, 5, and 7, and 40mg of docetaxel plus 50mg of CDDP in case 4, respectively [8].
At the completion of HIPEC, intraperitoneal port system was introduced. Second and third sessions of LHIPEC was done in case 1, 2, and 7 at 6 and 12 months and in case 9 at 6 and 12 months after the first session of LHIPEC. At every LHIPEC, PCI were examined. PCI counts at the 1st LHIPEC and the second LHIPEC or laparotomy after LHIPEC and IP chemotherapy were compared. Complications after LHIPEC were graded according to the classification established by Clavien PA and colleagues [9]. Two weeks after LHIPEC, Intraperitoneal (IP) chemotherapy from IP port system was performed. Forty mg of docetaxel and CDDP in 500 ml of saline was injected from IP port by two weeks interval (Table 3).
Statistical Analyses and the Approval By Ethical Committee
All patients were followed and no patients were lost to follow-up. Outcome data were obtained from medical records and patients’ interview. All statistical analyses were performed using SPSS software statistical computer package version 17 (SPSS Inc., Chicago, USA). The amount of ascites and PCI of the first and second LHIPEC were analyzed by student T-test. Statistical significance was defined as a p-value ≤0.05. The present study, entitled as a study of a comprehensive treatment for peritoneal surface malignancy was approved by the ethical committee of Kishiwada Tokushukai Hospital (H-19-2).
Results
Mean operation time of LHIPEC was 152 ± 15minutes, ranging from 142 to 212minutes. Intraoperative complications were not encountered. There was no mortality and morbidity of grade 3, or 4 after LHIPEC. Mean hospital stay was 3.5 days (range 3.7).
Changes of PCI.
PCI of the first LHIPEC was 24.1 ± 8.9, and that after LHIPEC plus IP chemotherapy using docetaxel and CDDP were 16.9 ± 8.3 (N=8). IP chemotherapy was done 3-24 cycles. There was a significant reduction of PCI after LHIPEC plus IP chemotherapy (P=0.0124). In case 1, 2, 5, and 7, treated with LHIPEC alone, all patients are alive without recurrence (case 1) or with disease (case 2, 5, and 7). Patients (case 3 and 4) received CCR-0 resection by peritonectomy were treated with LHIPEC and IP chemotherapy.
Histologic Findings
Microscopic examination showed that a papillary pattern accompanied by a glandular pattern, and the papillary areas were lined by a single cuboidal mesothelial cells (Figure 3), with one case (Figure 4, Case 8), having a mild nuclear atypia. In general, the mesothelial cells lacked mitotic activity. In addition, less than 1% of cells were positive for MIB-1 antibody (Figure 5). Immunohistologic studies showed a positive calretinine, CK7 (Figure 6) and D2-40 (Figure 7) and a negative CEA. In case 8, submesothelial invasive tumor of higher cytologic grade was detected in one of 23 sections from resected specimen.

Figure 3: Hematoxilin-eosin staining of case 4 (left) and case 1 (right).

Figure 4: Mild nuclear atypia was found in Case 8.

Figure 5: Immunohidtochemical findings by Ki-67 antibody (Case 8: left, and Case 1: right).

Figure 6: CK7 immunoreaction in case 4.
Figure 7: D2-40 immunoreaction in case 1.

Figure 8: Invasion foci found in Case 6. Atypical cells mimicking MPM invade into the submesothelial tissue (case 8).
Prognosis
Patients (case 1, 2, 5, and 7) treated by LHIPEC alone were alive with WDPM (case 2, 5, and 7) from 11 to 77 months or without WDPM (Case 1) after 92 months (Table 2). PCI of case 1 at the 1st LHIPEC was 3, but it was 0 at the second laparoscopy, performed 6 months after the 1st LHIPEC. PCI of case 2 at the 1st LHIPEC was 30 (Figure 9), and WDPM was completely disappeared at the 2nd laparoscopy (Figure 10). However, PCI of case 7 was not changed at the 1st LHIPEC (PCI of 36) and 2nd LHIPEC (PCI of 36). PCIs of Case 3 and 4 at the 1st LHIPEC were 15, and 16, and those at the laparotomy became 3 and 13. Accordingly, complete resection could be done in the two cases, and they are alive without recurrence. In contrast, PCIs of case 8 and 9 at the laparotomy were 26 and 23, and those could not be reduced by LHIPEC and IP chemotherapy to the levels to perform complete resection. Additionally, small bowel mesentery in these 2 cases was diffusely involved, Case 8 died of mesothelioma recurrence in pleural cavity and abdominal wall, and the histology showed MPM (Figure 11). Case 9 is alive with mesothelioma recurrence in peritoneal cavity and the pathologic diagnosis was biphasic type of DMPM. Case 5 committed suicide.

Figure 9: Laparoscopic finding of pelvic peritonealsurface Case 2.

Figure 10: Laproscopic finding of pelvic peritonealsurface six month after laparoscopic HIPEC and IP chemotherapy.

Figure 11: Histological finding of abdominal wall recurrence (Case 8) shows typical epithelioid type of malignant peritoneal mesothelioma.
Discussion
WDPM is a rare mesothelial disease, that preferentially occurs in the peritoneum of woman [5]. Most cases of WDPM are usually encountered as incidental findings at the time of operation for other diseases. According to the recent review of Deraco [10]. WDPM is unrelated to asbestos, and demonstrates a wide spectrum of clinical behavior, ranging from indolent course to transform DMPM, resulting in death Because of its rarity, no standard treatment has been proposed. Recently, Ling CH collected and studied 325 WDPM cases from the literatures. From a stand point of distribution of tumors, there are 3 types; i.e., single tumor, several small tumors on the peritoneal surface, and multiple nodules diffusely involved on the peritoneum. Ling CH reported that most cases with single tumor did not recur after simple resection [11], and these cases are believed to be benign. However, WDPM with multifocal foci tends to recur after local resection or incomplete ordinary surgical resection [10,11].
In the present study as case 1, showing several small nodules smaller than 6 mm, LHIPEC had a great role in the treatment. So far, there was no report about the treatment by LHIPEC for WDPM. The present study showed PCI was significantly reduced by LHIPEC plus IP docetaxel and CDDP administration. In experimental peritoneal dissemination model, Los G et al reported that the penetration distance of CDDP after 41.5 degree of HIPEC using CDDP reached to 2-3 mm from the peritoneal surface [12]. As histological finding shows WDPM cells are covering on the papillary myxoid cores in a single layer, these cells can be effectively heated by HIPEC. In our HIPEC, the intraperitoneal temperature maintains higher than 43 degree, and the cytotoxicity for WDPM cells must be higher than 41.5 degree. Additionally, LHIPEC and IP chemotherapy decreased PCI from 3 to 0, 30 to 0, 36 to 39, and 16 to16, in case 1, 2, 5, and 7, who were treated by LHIPEC plus IP chemotherapy.
PCI of patients who received CC-0 resection after LHIPEC plus IP chemotherapy change from 15 to 3 (case 3) and 16 to 13 (case 4). Additionally, cycles of IP chemotherapy in case 3, and 4 were 7 and 5 cycles. However, lesion size scores on small bowel mesentery could not reduced in case 8 and 9, resulting in performing incomplete cytoreduction. IP chemotherapy cycles of these patients were 3, and 0 cycles. From these results suggest that more than 5 cycles of IP chemotherapy are needed to reduce PCI levels and small bowel PCI levels to perform CC-0 resection. Deraco M et al. reported 45 WDPM patients were treated with cytoreductive surgery using peritonectomy technique plus intraoperative HIPEC. There were 4 deaths and 5 years overall survival was 80%, and 8 patients had disease recurrence. On univariate analysis preoperative CT, high PCI and severe morbidity associated with reduced survival. On multivariate analysis only preoperative CT (hazard ratio 32.6) and High PCI (HR=21.7) remained significant risk factors. As prognostic factor, Churg A proposed a invasive foci in the WDPM 13). Invasive foci include small bland-appearing mesothelial glands in a fibrotic stroma, solid or near solid areas of bland mesothelial cells, cytologically higher grade lesions appearing as sheets of atypical mesothelial cells or atypical cells forming glands, or invasion into the subperitoneal tissues. They alert that WDPM having these foci tend to have possibility of recurrence [13]. In the present study, case 8 shows submesothelial invasive foci of higher cytologic grade was detected in one of 23 sections from resected specimen. This case developed recurrence in abdominal wall 97 months after treatment, and the histology showed epitheliod type of MPM.
Case 9 did not have invasive foci, but she recurred in peritoneal cavity 67 months after incomplete cytoreduction + HIPEC. The histology showed biphasic type of DMPM. According to Ling CH, malignant transformation of WDPM to DMPM were reported in 5 of 325 patients [11]. Baratti D et al also reported a case of WDPM transformed to biphasic DMPM [14,15].
Conclusions
Most of solitary type or WDPM with several nodules are considered to have benign biological behavior, but multifocal type of WDPM has a highly malignant potential in some parts of the lesions. Complete cytoreduction of visible nodules after LHIPEC and IP chemotherapy combined with intraoperative HIPEC are essential for cure. However, multifocal WDPM patients who received incomplete resection may develop recurrence and transform DMPM. As WDPM have an indolent biological behavior, patients should be carefully followed longer than 5 years.
Referrences
- Sauter JL, Dacic S, Galateau-satlw F, Attanoos RL, Butnor KJ, et al. (2022) The 2021 WHO Classification of Tumors of the Pleura: Advances Since 2015 Classification. J Thoracic Oncol 17: 608-622.
- Deraco M, Bartlett D, Kusamura S, Baratti D (2008) Consensus statement on peritoneal mesothelioma. J Surg Oncol 98: 268-272.
- Prbhakaran S, Hussey M, O’Byrne KJ, Klebe S (2021) Progression of well-differentiated papillary mesothelial tumor to mesothelioma in a patient with Ehlers Danilos Syndrome. J Mole Pehol 2: 306-311.
- Kusamura S, Kepenkian V, Villeneuve L, Lurvink RJ, Govaerts K, et al. (2021) Peritoneal mesothelioma; PSOGI/EURACAN clinical practice guidelines for diagnosis, treatment and follow-up. EJSO 47: 35-59.
- Malpica A, Sant Ambrogio S, Deaver MT, Silva EG (2012) Welldifferentiated papillary mesothelioma of the female peritoneum; a clinicopahologic study of 26 cases. Am J Surg Pathol 36: 117-127.
- Sugarbaker PH (2008) Building on a consensus. J Surg Oncol 98: 215-216.
- Kuramoto M, Shimada S, Ikeshima S, et al. (2009) Extensive intraoperative intraperitoneal lavage as a stamdard prophylactic strategy for peritoneal recurrence in patients with gastric cancer. Ann Surg 250: 242-246.
- Kusamura S, Kepeneken V, Villeneuve L, Lurvink RJ, Govaerts K, et al. (2021) Peritoneal mesothelioma: PSOGI/EURACAN clinical practice guidelines for diagnosis, treatment and follow-up/ EJSO 47: 36-59.
- Clavien PA, Barkun J, de Oliveira ML, Vauthey JV, Dindo D et al. (2009) The Clavien-Dindo classification of surgical complications: fiveyear experience Ann Surg 250: 187-96.
- Deraco M, Nizzi E, Glehen O, Baratti D, Tuech JJ, et al. (2019) Well differentiated papillary peritoneal mesothelioma treated by cytoreduction and hyperthermic intraperitoneal chemotherapy -the experience of the PSOGI registry. EJSO 45: 371-375.
- Ling CH, Ishibashi H, Fujita T, Liu Y, Wakama S, Sako S, Kitai T, Hirono Y, Taniguchi iK, Fujimoto D, Cen YC, Yonemura Y. International J Innovative Surgery. ISSN:2639-9229,
- Los G, van Vugt MJ, Pinodo HM (1994) Response of peritoneal solid tumors after intraperitoneal chemohyperthermiatreatment with cisplatin or carboplatin. Br J Cancer 69: 235-241.
- Churge A, Allen T, Borczuk AC, et al. (2014) Well-differentiated papillary mesothelioma with invasion foci. Am J Surg Pathol 38: 990998.
- Baratti D, Kusamura S, Nonaka D (2007) Multicystic and welldifferentiated papillary peritoneal mesothelioma treated by surgicall cytoreduction and hyperthermic intra-peritoneal chemotherapy (HIPEC). Ann Surg Oncol 14: 2790-2797.
- Kim MJ, Moon EJ, Park YJ, Roh JW, Park YS, et al. (2001) A case of well-differentiated papillary mesothelioma developing malignant mesothelioma with seeding mass on the trocar insetion site of diagnostic lapaoscopicy and malignant change. Cancer Res ansd Treat 33: 457-361.
© by the Authors & Gavin Publishers. This is an Open Access Journal Article Published Under Attribution-Share Alike CC BY-SA: Creative Commons Attribution-Share Alike 4.0 International License. Read More About Open Access Policy.